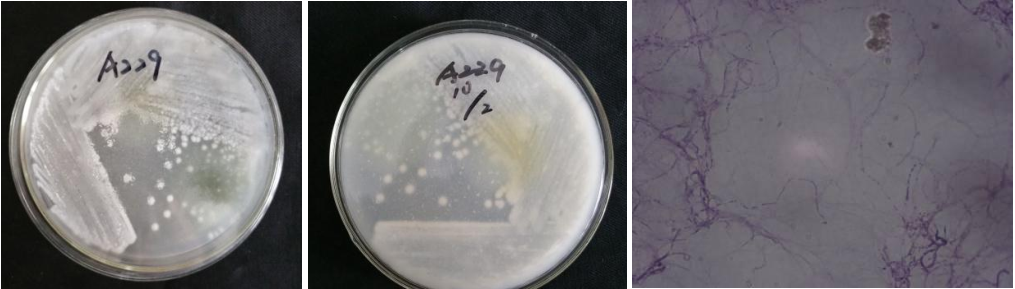

Loading...
| StrainNO | A229 |
| Classification | Streptomyces |
| 16s rDNA sequence | |
| Strain Morphology Photos | |
| Morphological Description | spore filaments:straight or curved;broken into barrels or nearly round spores;old filaments:large vacuoles;protoplasm:highly condensed;Spore pile:milky white;back:ivory yellow |